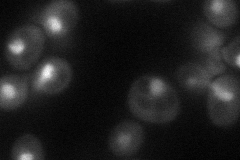
YKL043W
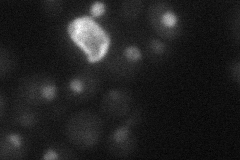
YKL043W
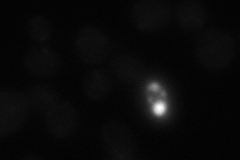
YKL043W
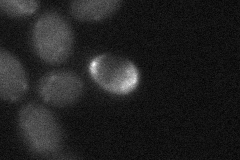
YKL043W
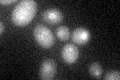
YKL043W

View description
Transcriptional activator that enhances pseudohyphal growth; regulates expression of FLO11, an adhesin required for pseudohyphal filament formation; similar to StuA, an A. nidulans developmental regulator; potential Cdc28p substrate
Localization:
Intensity:
Fold change:
Significance:
-
C’ GFP library in SD

nucleus27.24 -
N' NOP1pr-GFP in SD
nucleus44.8159 -
N' TEF2pr-mCherry in SD
nucleus13.5343 -
N' NATIVEpr-GFP in SD
below threshold18.8811 -
N' TEF2pr-VC and Cyto-VN in SD
below threshold22.9536 -
C’ GFP library in SD+DTT

nucleus19.150.7Yes -
C’ GFP library in SD+H2O2

nucleus29.181.07No -
C’ GFP library in Starvation Media
nucleus30.041.1No -
C’ GFP library on the background of Pup2-DaMP

N/A -
C’ GFP library on the background of CCT mutant

N/A0N/AYes
